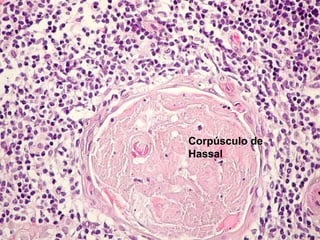
Corpúsculo de
Hassal

El timo es un órgano del sistema linfático que se desarrolla en el embrión y madura los linfocitos T. En la adultez disminuye de tamaño debido a la atrofia y es reemplazado por tejido adiposo. Tiene función endocrina secrentando hormonas como la timolina y timopoyetina. Enfermedades como la miastenia gravis y el timoma afectan al timo.